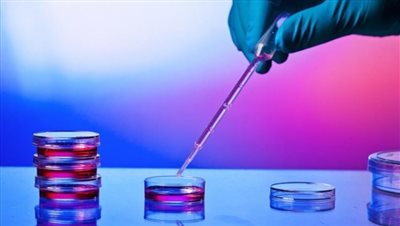

«Πράσινο φως» στο πρώτο φάρμακο βλαστοκυτταρικής θεραπείας
Η χρήση βλαστοκυττάρων για την αντιμετώπιση μιας σπάνιας πάθησης που μπορεί να οδηγήσει σε τύφλωση έτυχε θετικής εισήγησης από τις αρμόδιες ευρωπαϊκές αρχές, ανοίγοντας νέους δρόμους στην Ιατρική.
Η ανεπάρκεια επιχείλιων βλαστοκυττάρων εξαιτίας φυσικών ή χημικών εγκαυμάτων στο μάτι θα αντιμετωπίζεται σύντομα με το πρώτο φάρμακο βλαστοκυτταρικής θεραπείας που λαμβάνει το «πράσινο φως» στην Ευρώπη.
Το Holoclar που ανέπτυξαν η Chiesi Farmaceutici SpA και η Holostem Terapie Avanzate είναι ένα φαρμακευτικό προϊόν προηγμένης θεραπείας το οποίο περιλαμβάνει ζωντανό ιστό που λαμβάνεται με βιοψία από περιοχή του κερατοειδούς του ματιού του πάσχοντος όπου δεν υπάρχει βλάβη και κατόπιν καλλιεργείται στο εργαστήριο.
Στις χώρες της Ε.Ε η συγκεκριμένη πάθηση LSCD (limbal stem cell deficiency) προσβάλει 3,3 στα 100.000 άτομα, ποσοστό μικρότερο από αυτό που θέτει ως όριο η Ευρωπαϊκή Οδηγία 141/2000 (5 ανά 100.000) όμως δεν είναι από αυτές που πρέπει κανείς να παίρνει αψήφιστα καθώς πέραν του οφθαλμικού πόνου και της μειωμένης όρασης, αν η κατάσταση αφεθεί όπως έχει ο ασθενής κινδυνεύει να τυφλωθεί…
Η πρόσφατη θετική εισήγηση για υπό προϋποθέσεις, σε πρώτη φάση, χρήση του Holoclar από την αρμόδια επιτροπή Φαρμακευτικών Προϊόντων για Ανθρώπινη Χρήση (CHMP) της Ευρωπαϊκής Υπηρεσίας Φαρμάκων EMA (European Medicines Agency) ήταν το πρώτο –ιστορικό– βήμα. Τώρα, το σκεύασμα θα πρέπει να πάρει την έγκριση και της Κομισιόν, προκειμένου να επιτραπεί η κυκλοφορία του σε όλες τις χώρες της Ευρωπαϊκής Ένωσης.
Σημειώνεται ότι για την πλήρη έγκριση χρήσης του νέου σκευάσματος θα απαιτηθούν περαιτέρω μελέτες και περισσότερο ολοκληρωμένα στοιχεία εκ μέρους της φαρμακευτικής εταιρίας.
iatropedia